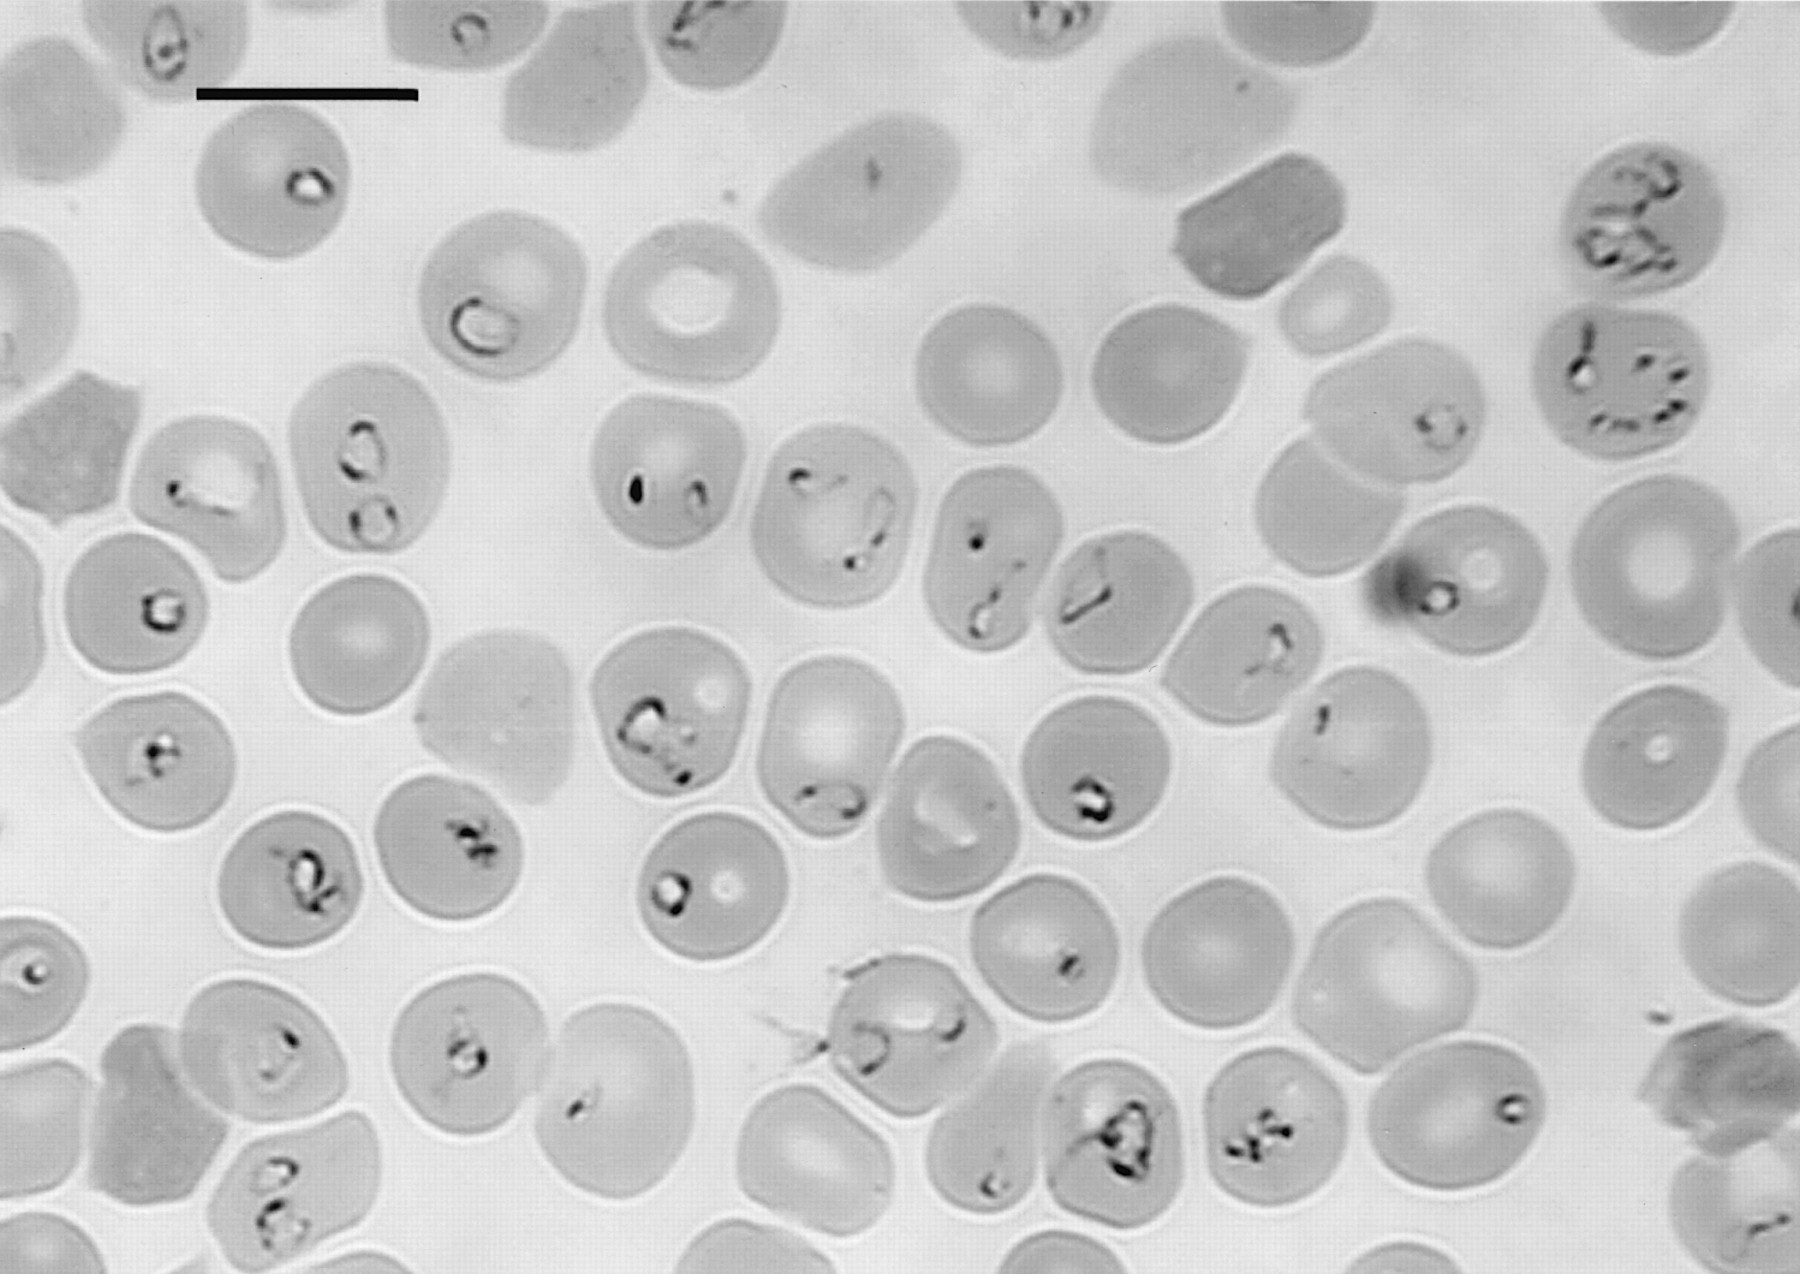

Во Словенија е забележан прв случај на заболен човек од бабезиоза, ретка болест слична на маларија, која во некои од случаи може да биде смртоносна.
Станува збор за инфекција од паразитите од родот Babesia, која ја пренесуваат крлежи и ги напаѓа црвените крвни зрнца, а инаку е присутна првенствено кај животните. Во Европа се забележани само неколку случаи од пренесување на бабезиоза на човек, пишуваат денес словенечките медиуми.
Дека се работи за прв забележан случај од таа ретка болест кај човек во Словенија, било утврдено со анализата на крвта на пациентката која неодамна била примена во болница. Имала висока температура и болки во мускулите.
Во крвта и биле пронајдени паразити – предизвикувачи на бабезиоза, што потврдила и дополнителната анализа објавена на Медицинскиот факултет во Љубљана.
Во Словенија крлежите многу почесто на луѓето пренесуваат лајмска борелиоза, исто така опасна болест. Годишно во Словенија се пријавуваат илјадници вакви случаи.
Republika.mk - содржините, графичките и техничките решенија се заштитени со издавачки и авторски права (copyright). Крадењето на авторски текстови е казниво со закон. Дозволено е делумно превземање на авторски содржини (текст и фотографии) со ставање хиперлинк до содржината што се цитира.